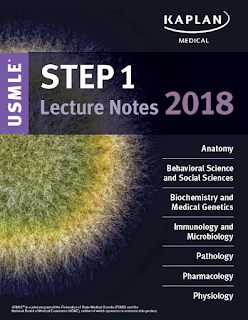

USMLE 2018 Step 2: LECTURE NOTES
As any medical student knows, the U.S. Medical Licensing Exam is a grueling set of tests that you must pass to practice medicine professionally in the U.S. If you’re looking past Step 1 to what lies ahead, understanding the structure and content of the USMLE Step 2 Clinical Knowledge (CK) will help you approach this next hurdle with confidence.
What Step 2 CK Is
Step 2 CK assesses a medical student’s ability to apply science knowledge in a clinical setting. It is a multiple-choice, computer-based examination that lasts about nine hours over the course of a single day. The content covers two primary areas of knowledge — physician tasks and disease categories.
When You Should Take Step 2 CK
The best time to tackle this next assessment is when clinical science knowledge is still fresh in your mind — and when you also have enough time in your schedule to study properly. Since Step 2 CK generally requires less preparation than Step 1, most medical schools don’t set aside dedicated time for students to get ready.
The length of time you may need to prepare for the test will vary depending on your goals. For those testers who require a strong Step 2 CK score, such as aspiring physicians who are applying to competitive specialties or who need to improve on a low USMLE Step 1 score, two to three months of study may be required. For those who simply need to pass the exam, a month is, in many cases, sufficient.
Medical schools that follow a traditional curriculum structure suggest taking Step 2 CK once core clinical rotations are complete. That is usually late in the third year or early in the fourth year. Those medical schools shifting to a newer program structure that moves clinical experience earlier in students’ education and integrates it with related coursework typically recommend sitting for this component anytime between the end of the first year and graduation. Each individual school provides guidance to its students.
How You Can Prepare
There are a variety of preparation resources that students can turn to in order to get ready for Step 2 CK. These fall into three broad categories:
1. Prep Courses
Live test prep courses offer structured classroom lectures and preparation materials.
Your Medical School
Some medical schools offer prep courses as part of the curriculum. These are a valuable resource for students. Definitely take advantage of this opportunity if your school provides it.
Private Courses
There are a number of well-known companies that offer Step 2 CK courses, much like there are many that offer MCAT preparation. The traditional test-prep companies, like Kaplan and Princeton Review, have a range of options as well as question banks and guidebooks.
That said, there are smaller companies whose courses often receive higher reviews, such as USMLE Success Academy, Doctors in Training, and Becker Reviews.
Please note that you do not need to take a live course to excel at USMLE Step 2 CK. Courses are a great option for students who tend to be successful given structure and a defined program and schedule. If you choose to enroll in a course, inquire about the timeline, study materials, teachers’ backgrounds, student-to-teacher ratio, and the company’s success rate for each class you’re considering. Courses can run into the thousands of dollars, so be sure you’re getting exactly what you need if you do decide to go this route.
Follow this link to find out whether group or individualized tutoring is better for your needs.
2. Question Banks
Question banks are essential for Step 2 CK preparation. They provide hundreds of practice questions that you can take — either timed or untimed — as full tests, blocks, or by category. They also offer explanations for each answer.
USMLE Free Practice Questions
USMLE annually offers Step 2 CK free practice test items that include a tutorial, overview, and question blocks. Many students use this resource as a starting point for studying so they can quickly learn how to navigate the test’s computer system and get comfortable with the question style. Note that this program can only be used on a PC.
NBME Self-Assessment Exams
NBME offers a comprehensive clinical science self-assessment (CCSSA) for $50. This resource, in conjunction with the USMLE free practice questions, will provide you with an early assessment of where you stand and highlight areas that may need extra attention in your USMLE Step 2 CK preparation.
Proprietary Question Banks
There are many companies that offer proprietary question banks. Several of the most popular are UWorld, Kaplan QBank, USMLE Consult, and USMLE Rx Qmax.
Free Question Banks
In addition, you can find free question banks if you are willing to scour the web and cobble together resources. Ben White, then a medical resident, gathered an excellent set of these resources that he shared with readers of his blog. Still, pulling free questions together from multiple online sources is a time-consuming undertaking, and your time is probably better served by paying (if you are able) for the formal resources so you can devote more of it to studying.
3. Study Guides
Unlike with Step 1, for which most current and former medical school students agree that First Aid for the USMLE Step 1is a must-have resource, the best general preparation book for the USMLE Step 2 CK is not widely agreed-upon. That said, there are several very popular options:
Kaplan USMLE Step 2 CK Lecture Notes
Kaplan Medical USMLE Master the Boards Step 2 CK
First Aid for the USMLE Step 2 CK
Step Up to USMLE Step 2 CK
Subject Books
Many board preparation books exist for each subject area, but students should avoid studying from 20 books at the same time. Instead, the best strategy is to use a single board book while you are learning that subject in clinical rotations. Afterward, transfer the notes you took in each subject book into your main review book when you begin Step 2 CK preparation. Kaplan Lecture Notes rate highly in most subjects; you can also find others that are effective. Here is a list of the most popular Step 2 CK books by subject:
Internal Medicine: “Step Up to Medicine” or “Master the Boards – Internal Medicine”
Pediatrics: “Blueprints Pediatrics,” “Kaplan Medical Master the Boards – Pediatrics,” or “Case Files Pediatrics”
Surgery: “Surgical Recall” or “NMS Surgery”
Obstetrics & Gynecology: “Blueprints Obstetrics & Gynecology” or “Case Files Obstetrics & Gynecology”
Psychiatry: “Deja Review Psychiatry” or “Blueprints Psychiatry”
Neurology: “Blueprints Neurology “ or “Case Files Neurology”
Preparation Strategies
Once you’ve decided whether you are taking a course and which question bank and books you’ll be using to study, you can start practicing for the test. I highly recommend these strategies:
As noted above, begin by using board books as you are taking a course in the subject. For example, while you are in your internal medicine rotation, review “Step Up to Medicine.”
Before you start prepping, create a schedule that includes breaks, time to eat, and days for taking full practice tests. And if the schedule that you’re using isn’t working, change it to make room for each activity. They’re all important!
Take a practice test early in your preparation process to see where you stand.
Complete as many practice questions as you can. Go through your question bank — and then repeat!
Take as many full-length practice tests as possible in a test-like setting to ensure you’re finishing blocks in the allotted 60 minutes — and to give your body the chance to acclimate to a very long day. Prometric Test Centers allow you to take a USMLE practice test for a fee that ranges from $75 to $266, depending on where you are taking it. And the opportunity is worthwhile. Schedule it a month or more in advance of your actual test date so you have enough time to sharpen your skills if the test doesn’t go as you’d hoped.
Study the topics that you don’t know. Many students slip into the habit of studying the subjects they’re already confident in — but if you’ve mastered a subject, spend time focusing on areas that give you trouble.
Study with a friend, and use mnemonics (even humorous ones) to help you memorize the material. Remember, the amygdala (emotion) is connected to the hippocampus (memory).
Take breaks in your study day. Get outside. Exercise.
If you are retaking the test, focus your preparation on the areas where you struggled. Thankfully, the score report from your previous test provides graphical performance profiles for each category. These will allow you to see where you need to concentrate your efforts.
Which Test-Taking Strategies You Should Master
When the test day arrives, here are some tips to help you get through Step 2 CK with confidence:
Know how to get to the test site. Do a practice run in advance. There is nothing worse than feeling rushed on the morning of the test.
Get to the test site at least 30 minutes early, and be sure to have a current picture ID with your signature, along with a printed copy of your scheduling permit.
Bring a lunch, snack, and ear plugs.
Answer every question. Wrong answers do not count against you.
Think of the exam as eight mini-tests — that is, eight blocks of 40 or so questions each.
Focus solely on the block you are in, complete it, clear your mind, and move to the next block.
Be sure you have checked all the questions in a block before hitting “end.” Once a block has ended, you cannot re-enter it to review your answers.
Add to your break time by skipping the optional 15-minute tutorial. At this point, you should be so familiar with the test that you won’t need the tutorial — but in the midst of a very long testing day, an extra break will likely be welcome.
Decide your plan for breaks ahead of time, and practice the strategy. For example, you could try one of the following plans:
Complete two blocks, take a 10-minute break, complete two blocks, take a 30-minute lunch break, complete two blocks, take a 10-minute break, complete two block. Complete four blocks, take a quick lunch break, and return to complete the final four blocks.
Whatever test-taking strategy you choose, perform it over and over on practice tests to simulate the real test environment, and to train your body to become accustomed to the challenge of a long test day.
If you can, get a great night’s sleep the night before the exam. Anecdotally, students and admissions counselors report that this night of sleep is an important and easily accomplished test-prep goal.
Though the USMLE Step 2 CK is one more component of this demanding exam series, with diligent and focused work, it is possible to be prepared and confident on test day.
Very best of luck!
TO DOWNLOAD THE BOOK, CLICK THE LINK BELOW